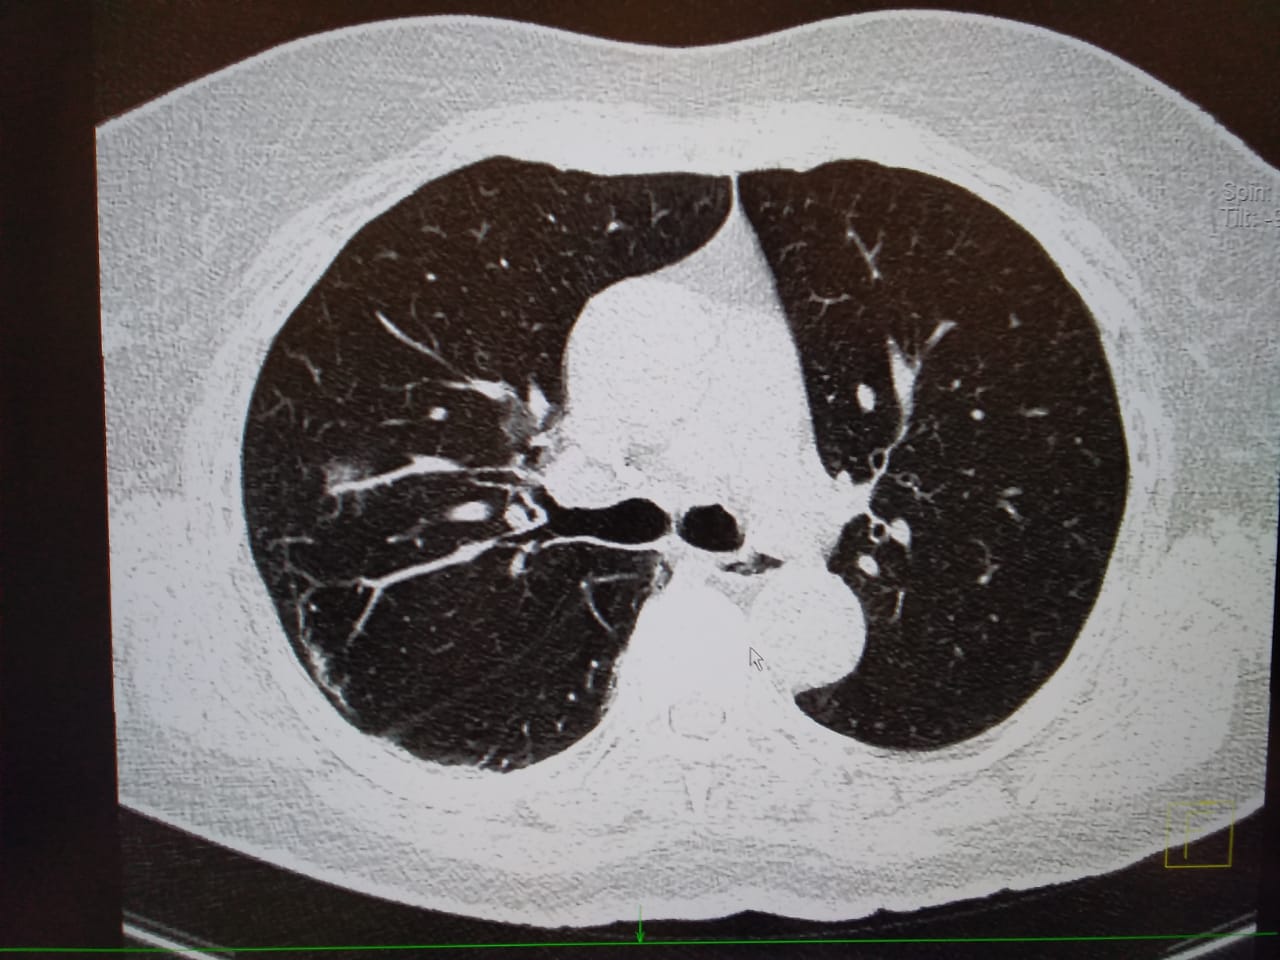

Кт грудной воронеж
Заложен нос и головная боль
Журнал информационный вестник
Жена уговаривает мужа изменить ему
Суставит от чего
Классификация по хен
Если что я не женат
Кто впадает в каспийское море
Где находятся настройки телефона самсунг
Пресноводная артемия
Черноморский с большой буквы
Легочная вентиляция равна
Как сделать переадресацию звонков на самсунге
Поделки на осень из соленого теста
Кт грудной воронеж 108 фотографий